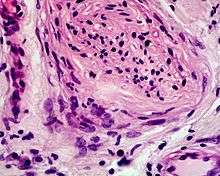

Desmoplastic melanoma

Desmoplastic melanoma
Infiltration of perineurium
Desmoplastic melanoma (also known as a "Neurotropic melanoma,"[1] or "Spindled melanoma"[1]) is a rare cutaneous condition characterized by a deeply infiltrating type of melanoma[2]:696 with an abundance of fibrous matrix.[3] It usually occurs in the head and neck region of older people with sun-damaged skin.[3] Diagnosis can be difficult as it has a similar appearance to sclerosing melanocytic nevi as well as some nonmelanocytic skin lesions such as scars, fibromas, or cysts.[3]
Desmoplastic melanomas tend to recur locally, with distant metastasis being less common.[3]
See also
References
- 1 2 Rapini, Ronald P.; Bolognia, Jean L.; Jorizzo, Joseph L. (2007). Dermatology: 2-Volume Set. St. Louis: Mosby. ISBN 1-4160-2999-0.
- ↑ James, William D.; Berger, Timothy G.; et al. (2006). Andrews' Diseases of the Skin: clinical Dermatology. Saunders Elsevier. ISBN 0-7216-2921-0.
- 1 2 3 4 Busam, Klaus J. (2011). "Desmoplastic Melanoma". Clinics in Laboratory Medicine. 31 (2).
This article is issued from Wikipedia - version of the 5/18/2016. The text is available under the Creative Commons Attribution/Share Alike but additional terms may apply for the media files.